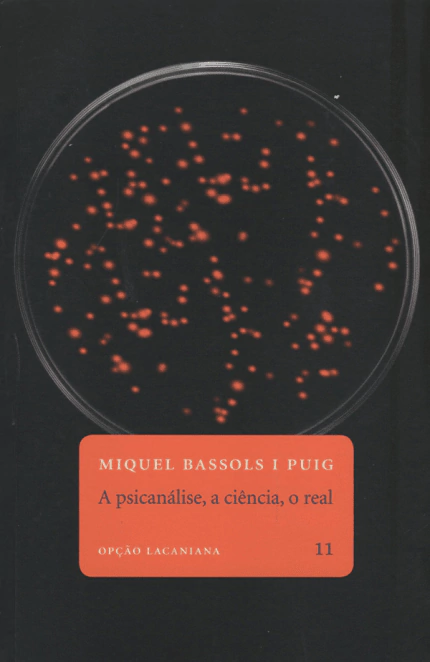
A psicanálise, a ciência, o real - Opção lacaniana 11

-

- (31) 9 9951-1789 ou (31) 3223-1789
- [email protected]
- Início
-
Produtos
- Editora Scriptum
-
Livros
- Administração
- Arquitetura
- Artes, teoria e crítica
- Auto-ajuda
- Biografia
- Ciências
- Ciências Sociais
- Cinema
- Comunicação e Jornalismo
- Dança
- Design
- Dicionário
- Direito
- Economia
- Esportes
- Estudos clássicos
- Ficção
- Filosofia
- Gastronomia
- História do Brasil
- História
- Infantil
- Infantojuvenil
- Judaismo
- Linguistica
- Literatura Brasileira
- Literatura Estrangeira
- Livros Importados
- Moda
- Medicina
- Música
- Pedagogia
- Poesia
- Psicanálise e Psicologia
- Quadrinhos
- Raridades
- Religião
- Teatro
- Teoria e Crítica Literária
- Turismo
- Coleções
- Ofertas & Promoções
- Ecobag
- Galeria de Arte
- Meio ambiente
- Fotografia
- Fotografia
- Contato
- Quem somos
- Termos de uso e condições
- Perguntas Frequentes
- Início
- > Livros
- > Psicanálise e Psicologia
- > A psicanálise, a ciência, o real - Opção lacaniana 11
A psicanálise, a ciência, o real - Opção lacaniana 11
Divididos em cinco partes, os 25 textos que compõem este primeiro livro em português de Miquel Bassols i Puig partem do real da psicanálise e a ele retornam de diferentes maneiras. Afeiçoados por uma prosa segura, serena e, quando preciso, irônica, eles buscam delimitar, entre os mundos simbólicos da ciência e da arte, a singularidades da descoberta do inconsciente por Sigmund Freud, à luz das ressonâncias causadas pelo ensino de Jacques Lacan. Como se aprende ao lê-los, a despeito das recorrentes e infrutíferas tentativas hoje empregadas no afã de localizar o Eu e a consciência em genes ou neurônios, sabe-se lá se no intuito de salvaguardá-los dos efeitos do inconsciente, o real da psicanálise surge quando se perturbam os campos da linguagem e da sexualidade.
Produtos similares
| 1 x de R$89,90 sem juros | Total R$89,90 | |
| 2 x de R$44,95 sem juros | Total R$89,90 |











Enviamos suas compras
Entrega em todo o país
Pague como quiser
Cartões de crédito ou à vista no Pix
Compre com segurança
Seus dados sempre protegidos
Enviamos suas compras
Entrega em todo o país
Pague como quiser
Cartões de crédito ou à vista no Pix
Compre com segurança
Seus dados sempre protegidos
Contato
- (31) 9 9951-1789 ou (31) 3223-1789
- [email protected]
- Rua Fernandes Tourinho, 99 - Belo Horizonte (MG)